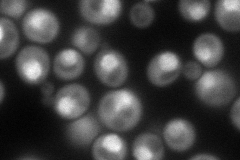
YDR395W
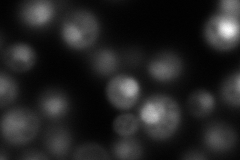
YDR395W
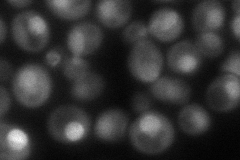
YDR395W
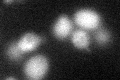
YDR395W

View description
Nuclear transport factor (karyopherin) involved in protein transport between the cytoplasm and nucleoplasm; similar to Nmd5p, Cse1p, Lph2p, and the human cellular apoptosis susceptibility protein, CAS1
Localization:
Intensity:
Fold change:
Significance:
-
C’ GFP library in SD

cytosol17.98 -
N' NOP1pr-GFP in SD
nucleus,nuclear periphery127.252 -
N' TEF2pr-mCherry in SD
nucleus125.886 -
N' NATIVEpr-GFP in SD
nucleus98.3273 -
N' TEF2pr-VC and Cyto-VN in SD

nucleus61.5255 -
C’ GFP library in SD+DTT
cytosol17.860.99No -
C’ GFP library in SD+H2O2

cytosol16.420.91No -
C’ GFP library in Starvation Media

cytosol16.550.92No -
C’ GFP library on the background of Pup2-DaMP

cytosol -
C’ GFP library on the background of CCT mutant

cytosol16.78010.932746No
